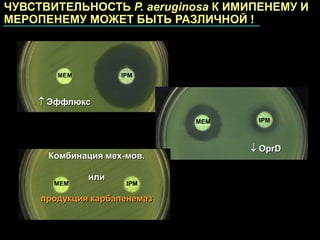

Имипенем Меропенем Отличия

⚡ 👉🏻👉🏻👉🏻 ВСЯ ИНФОРМАЦИЯ ДОСТУПНА ЗДЕСЬ, КЛИКАЙ 👈🏻👈🏻👈🏻
имипенем или меропенем что лучше
Меропенем и имипенем и амикацин
Карбапенемы . Механизм действия, фармакокинетика, показания . . .
Имипенем: инструкция по применению, цена и аналоги . . .
меронем и меропенем в чем разница
Меропенем - thelib .info
Меропенем Имипенем
Имипенем и карбапенем
Мерофен Меропенем Тариа Usp - Монфа Трейд Ххк
Имипенем механизм действия . Карбапенемы: спектр действия . . .
Вемурафениб Зелбораф
Бисопролол Цена В Челябинске
30 Перекись Водорода Из Гидроперита
Имипенем или меропенем что лучше . Карбапенемы (имипенем и меропенем) относятся к β-лактамам .По сравнению с пенициллинами и цефалоспоринами, они более устойчивы к гидролизующему действию бактериальных β-лактамаз, в . . .
К настоящему времени известно более 40 природных и синтетических соединений этой группы, однако для клинического применения используются только несколько препаратов: имипенем, меропенем, биапенем и панипенем . . .
Карбапенемы (имипенем и меропенем) относятся к β-лактамам . Они более устойчивы к гидролизующему действию бактериальных β-лактамаз
Меропенем Тиенам Комбинация Имипенем + Циластатин входит в состав следующих препаратов: Аквапенем, Имипенем и Циластатин, Тиенам, Имипенем и циластатин натрия, Имипенем + Циластатин-Виал, Цилапенем, Гримипенем, Циласпен, Тиепенем . Отзывы Отзывов о препарате немного, однако, отрицательных не обнаружено .
С .В .Яковлев, В .П .Яковлев Московская медицинская академия им . И .М .Сеченова, Институт . . .
Имипенем (но не меропенем) проявляет конкурентный антагонизм с ГАМК, поэтому может оказывать дозозависимое стимулирующее действие на ЦНС
Показания к применению Меропенема Антибиотики (производные карбапенема) . Осложненный аппендицит или перитонит, вызванные Escherichia coli, Klebsiella pneumoniae, Pseudomonas aeruginosa, Fragillis bacterioid, Tetiotamicron bacterioid, Peptostreptococcus, а также . . .
Имипенем е известен също с търговското наименование ZienamR . Ефект Карбапенемите (меропенем, имипенем) са сред най-широко използваните антибиотици и достигат почти всички грам-положителни и отрицателни патогени .
Мерофен(Меропенем) нь хүний дегидропептидаза-1 (ДГП-1)-д харьцангуй тогтвортой, нэмэлт ДГП-1 . . .
ᐉ Имипенем механизм действия . Карбапенемы: спектр действия, показания, побочные эффекты . . .
Нолипрел А Форте Цена В Волгограде
Интерферон Офтальмо Капли Глазные Отзывы
Дексалгин 25мг Цена
Таблетки От Кашля Горпилс
Дюфастон Москва
Эликвис Или Дипиридамол Разница
Панангин Форте Алла Форте
Сколько Колоть Окситоцина Кошке При Родах
Ацц И Флуифорт Совместимость
Тиоктовая Кислота Мннн
Сколько Курс Лечения Лазолваном
Лекарство Эдарби 40
Органическая Спирулина
Эхинацея Пурпурная Green Twister
Виферон Свечи Для Детей Цена Тула
Вазаламин Реальные Отзывы Форум
Капли Таптиком Цена
Аналог Свечи Виброцил
21 Век Промывание Миндалин
Постинор Побочные Действия
Пентаксим Без Гемофильной
Лазолван Сироп Для Детей Цена Отзывы
Изофра Или Протаргол Что Лучше Для Детей
Кристаллическая Решетка Хлорида Кальция Металлическая Молекулярная
Диклофенак Свечи Цена Отзывы Аналоги
Прадакса Мочи
Пульмикорт Для Ингаляций Можно При Температуре
Витабакт Или Офтальмоферон
Ипратерол От Чего Помогает
Цитрамон И Коньяк Совместимость
Пиносол Инструкция По Применению Цена Отзывы
Билобил От Чего Помогает Отзывы
Посадка Гинкго Билоба Семенами
Зиртек И Кетотифен Одновременно
Римантадин Таблетки Отзывы Врачей И Пациентов
Доксициклин Против Прыщей
Саксенда Недорого
Нистатин Таблетки Отзывы Врачей
Хлорид Кальция Для Приготовления Творога
Глицин Форте Эвалар Форум
Лютеин Форте
Но Шпа При Пониженной Температуре
Укол Иммуноглобулина При Беременности
Обезболивающие Уколы Фламакс
Капли От Горла Тонзилгон Отзывы
Превенар Прививка Нужна Ли
Нистатин Таблетки Производство
После Фемилекса Можно
Капилар Цена Симферополь
5 Нтр Эвалар Отзывы Покупателей И Врачей
Кальциум Плюс Отзывы
После Приема Дюфастона Нет Месячных Причины
Индол Карбинол Отзывы Врачей
Когда Появится Эутирокс В Аптеках Набережных Челнов
Солгар Омега 2000
Компливит Аква Д3 Сколько Капель
Брустан Цена
Топотекан Цена В России
Спазмалгон От Боли В Мышцах
Пропафенон Россия
От Кашля Кофасма Для Детей
Исанцеали Цена Эссенциале Форте
Мазь Хондролон Инструкция По Применению
Фрагмин Ребенку
Ли Монурал
Ксарелто Лекоптторг СПб
Аптека Флебофа
Оземпик Инструкция Аналоги
Лапчатка Непальская Сеем
Лозартан Ковид
Для Чего Принимают Уколы Мидокалм
Циннаризин Или Мексидол
После Смекты Зеленые
Венлафаксин Видаль
Лекофен Комбо С Какого Возраста
Сколько Колоть Мильгамму Отзывы
Девясил От Болей
Линекс Цена В Барановичах
Телмисартан Инструкция Цена В Москве
Перфектил Плюс 28 Табл 28 Капс
Элина Камирен Видео Дом
Донормил Пью Три Года
Ревалид Для Волос Цена В Аптеке
Лориста 5мг
Хофитол Таблетки Противопоказания
Доксициклин При Хроническом Простатите
Эдарби Кло 80 12.5
Диклофенак Цена Таблетки 100
Коронавир Таблетки Это Антибиотики Или Нет
Нитроксолин При Простатите
Диклофенак Действующее
Омник Окас Инструкция Отзывы Врачей
Пропустила 24 Таблетку Джес Плюс
Антибиотики Циклофосфан
Индапамид И Индапамид Штада Разница
Мовалис Уколы Аналоги Дешевле Цена В Рублях
Супрадин Стоит
Глюконат Кальция Оптом
Голдлайн 10 Мг Отзывы 2022
Лазолван От Давления
Имипенем Меропенем Отличия












































/oins182-3_1218_f2.jpg)